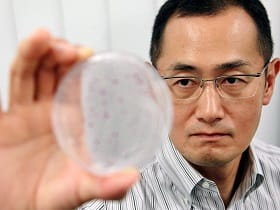

幕末
1850年代

ペリー浦賀来航(1853)
1860年代
明治

明治に改元(1868)
1870年代

新橋ー横浜間で日本初の鉄道開業(1872)

官営富岡製糸場開業(1872)
1880年代

鹿鳴館開館(1883)

大日本帝国憲法発布(1889)
1890年代

日清戦争(1894)
1900年代

田中正造、足尾鉱毒を天皇に直訴(1901)

日露戦争(1904)
1910年代
大正

スペイン風邪大流行(1918)
1920年代

関東大震災(1923)

日本初のラジオ試験放送始まる(1925)

ペリー浦賀来航(1853)

明治に改元(1868)

新橋ー横浜間で日本初の鉄道開業(1872)

官営富岡製糸場開業(1872)

鹿鳴館開館(1883)

大日本帝国憲法発布(1889)

日清戦争(1894)

田中正造、足尾鉱毒を天皇に直訴(1901)

日露戦争(1904)

スペイン風邪大流行(1918)

関東大震災(1923)

日本初のラジオ試験放送始まる(1925)
昭和(戦前)
1920年代

第1回都市対抗野球大会(1927)

アムステルダム五輪(1928)
1930年代

満州事変(1931)

2・26事件(1936)
1940年代

真珠湾攻撃(1941)

学童疎開開始(1944)

第1回都市対抗野球大会(1927)

アムステルダム五輪(1928)

満州事変(1931)

室戸台風、近畿地方を直撃(1934)

2・26事件(1936)

国産機「ニッポン号」世界一周成功(1939)

真珠湾攻撃(1941)

学童疎開開始(1944)
昭和(戦後)
1940年代

マッカーサー元帥が厚木飛行場に(1945)

新選挙法による初の総選挙(1946)

日本国憲法公布(1946)

湯川秀樹博士にノーベル物理学賞(1949)
1950年代

対日講和条約・日米安全保障条約調印(1951)

テレビ本放送開始(1953)

ヘレン・ケラー女史が3度目の来日(1955)

東京タワー完成(1958)
1960年代

新安保条約調印(1960)

東京五輪(1964)

四日市で初の大気汚染公害訴訟(1967)

東大闘争(1968)
1970年代

アジア初開催の大阪万博(1970)

三島由紀夫が割腹自殺(1970)

第1次オイルショック(1973)

王貞治選手が756号本塁打(1977)
1980年代

「竹の子族」ブーム(1980)

グリコ・森永事件(1984)

日航ジャンボ機御巣鷹に墜落(1985)

JR誕生(1987)

マッカーサー元帥が厚木飛行場に(1945)

新選挙法による初の総選挙(1946)

日本国憲法公布(1946)

湯川秀樹博士にノーベル物理学賞(1949)

対日講和条約・日米安全保障条約調印(1951)

テレビ本放送開始(1953)

ヘレン・ケラー女史が3度目の来日(1955)

東京タワー完成(1958)

皇太子さま、美智子さまご結婚(1959)

新安保条約調印(1960)

日本初の大型横断歩道橋完成(1963)

東京五輪(1964)

四日市で初の大気汚染公害訴訟(1967)

東大闘争(1968)

アジア初開催の大阪万博(1970)

三島由紀夫が割腹自殺(1970)

札幌冬季五輪(1972)

第1次オイルショック(1973)

ロッキード事件で田中角栄前首相逮捕 (1976)

王貞治選手が756号本塁打(1977)

成田空港開港(1978)

「竹の子族」ブーム(1980)

ローマ教皇が初来日(1981)

ホテルニュージャパン火災(1982)

グリコ・森永事件(1984)

日航ジャンボ機御巣鷹に墜落(1985)

JR誕生(1987)

リクルート事件(1988)
平成
1980年代

平成に改元(1989)
1990年代

株価急落、バブル崩壊始まる(1990)

皇太子さま、雅子さまご結婚(1993)

阪神・淡路大震災(1995)

地下鉄サリン事件(1995)
2000年代

シドニー五輪(2000)

北朝鮮から5人の拉致被害者が帰国(2002)

JR福知山線脱線事故(2005)

リーマン・ショック(2008)
2010年代
令和

東日本大震災(2011)

広島土砂災害(2014)

オバマ米大統領が広島初訪問(2016)

新元号「令和」スタート(2019)
2020年代

新型コロナウイルス感染拡大(2020)

観客なき東京五輪(2021)

能登半島地震(2024)

女性初の首相に高市早苗氏
(2025)

平成に改元(1989)

株価急落、バブル崩壊始まる(1990)

毛利衛さん宇宙へ(1992)

皇太子さま、雅子さまご結婚(1993)

阪神・淡路大震災(1995)

地下鉄サリン事件(1995)

長野冬季五輪(1998)

東京都知事に石原慎太郎氏(1999)

大阪で全国初の女性知事誕生(2000)

シドニー五輪(2000)

米同時多発テロ(2001)

北朝鮮から5人の拉致被害者が帰国(2002)

愛・地球博(愛知万博)開幕(2005)

JR福知山線脱線事故(2005)

リーマン・ショック(2008)

東日本大震災(2011)

山中伸弥教授にノーベル生理学・医学賞(2012)

世界文化遺産に富士山(2013)

広島土砂災害(2014)

オバマ米大統領が広島初訪問(2016)

リオデジャネイロ五輪(2016)

平昌冬季五輪(2018)

新元号「令和」スタート(2019)

新型コロナウイルス感染拡大(2020)

観客なき東京五輪(2021)

侍ジャパン14年ぶりWBC制覇(2023)

能登半島地震(2024)

女性初の首相に高市早苗氏
(2025)